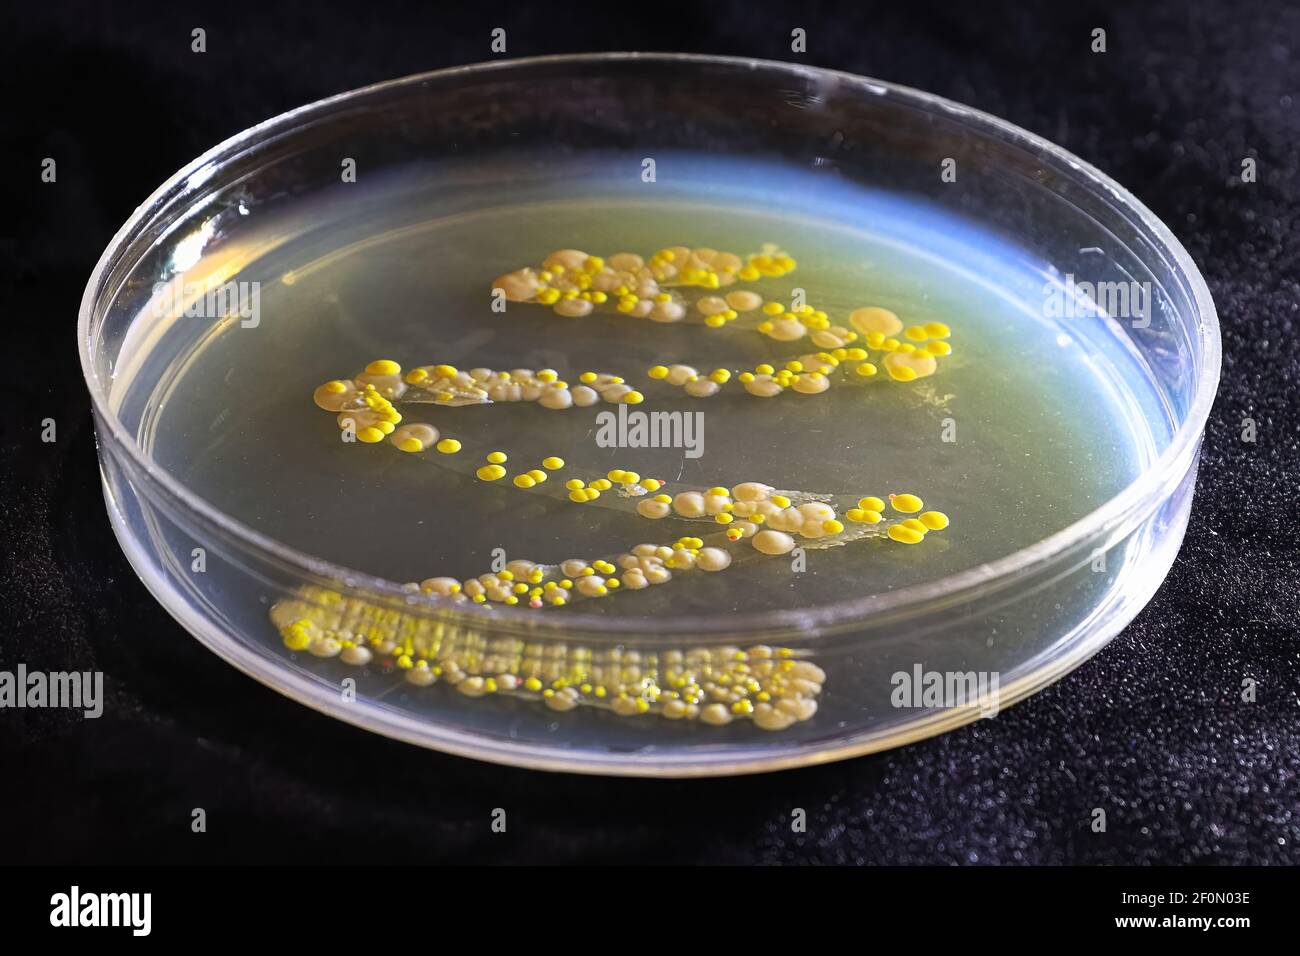
Una capsula di Petri con colonie comuni di lievito e batteri Foto Stock

Batteri comuni Immagini Stock
(1,863)Filtri rapidi:
Batteri comuni Immagini Stock

RME8KPGD–Batteri di Salmonella, una causa comune di avvelenamento di cibo, di invadere una cellula immune.

RFKG56GR–Batteri di forma sferica e a forma di asta batteri all'interno del biofilm, illustrazione del computer. Un biofilm è una colonia di batteri che si forma un rivestimento su una superficie. Luoghi comuni per biofilm da sviluppare sono in bocca, dove possono causare delle cavità del dente e malattie gengivali, su lenti a contatto, dove possono causare infezioni di occhio, sulle rocce sommerso in acqua e sulle attrezzature industriali, dove essi possono provocare incrostazioni.

RM2C6MYB7–Nancy Teo Quintana un primo grado studente dalla sig.ra Lindsay Gormus della classe in Maryland Città scuola elementare di alloro, Maryland guarda attraverso un microscopio per visualizzare la listeria e la salmonella, due dei quattro più comuni batteri presenti nei prodotti alimentari. Gli altri due sono i batteri campylobacter ed e. coli. Il Reparto di Stati Uniti dell'Agricoltura, sicurezza alimentare servizio di ispezione ha tenuto una educazione alla sicurezza alimentare il camp in Maryland Città scuola elementare, gio, 5 maggio 2011.

RMFJ5HFH–Di forsitia comune (coltivazione x intermedia, Forsitia intermedia), con fiele di batteri, Rhodococcus fascians, Germania, Meclemburgo-Pomerania Occidentale

RM2BE0JBJ–Scansione di una micrografia elettronica (SEM) di Enterococchi resistenti alla vancomicina (VRE). Ceppi dei batteri, Enterococchi, che sono resistenti all'antibiotico vancomicina, noto come Enterococchi resistenti alla vancomicina, sono stati trovati in Francia nel 1986. La malattia dovuta alle infezioni da VRE in persone sane è rara. Le infezioni comuni causate da enterococchi sono inezioni delle vie urinarie e infezioni delle ferite.

RM2NGXW9Y–STATI UNITI Air Force Airman 1st Class Tyler Benner, 86th Vehicle Readiness Squadron vehicle operator, posa per una foto alla base aerea di Ramstein, Germania, 30 novembre 2022. Benner ha affrontato e sopravvissuto ad una rara condizione medica che pochi hanno incontrato dopo mesi in ospedale. Aggregatibacter aphrophilus, un comune batterio residente in bocca, ha causato il suo sangue a diventare settico e ha portato alla crescita di un ascesso di baseball-dimensione nel suo fegato.

RM2BB46D6–ALIMENTAZIONE A MOSCA SU UNA SUPERFICIE DI LAVORO. UN'INCRINATURA SU UNA SUPERFICIE DI LAVORO È TERRENO FERTILE PER I BATTERI PERCHÉ IL CIBO PUÒ RACCOGLIERSI ALL'INTERNO DEL DANNO E DELLA SUPERFICIE USURATA. VOLA. LA CASA COMUNE VOLA, FLESHLIGHT VOLARE BLU E VERDE BOTTIGLIA MOSCHE SONO ABBONDANTI NEL REGNO UNITO SOPRATTUTTO NEI MESI ESTIVI PIÙ CALDI.

RMEHN71X–La Salmonella sp. batteri arruffata di cellule immunitarie. La Salmonella sp. i batteri sono una causa comune di malattie a trasmissione alimentare, scanning electron microfotografia (SEM).

RF2BRCFYJ–Scienza Foto di batteri Chlamydia è una malattia sessualmente trasmessa comune. È causato da batteri chiamati Chlamydia trachomatis

RF3CKYJYH–Diagramma di anatomia delle cellule batteriche con parti etichettate, tra cui Nucleoide, ribosomi, flagello e membrana al plasma.

RF2WAKNTW–Virus o batteri umani comuni isolati su sfondo bianco. Malattia delle cellule coronavirus infezione medicina vettore sanitario

RME8KPGH–Batteri di Salmonella, una causa comune di avvelenamento di cibo, di invadere una cellula immune.

RFJFEEC0–Batteri di forma sferica e a forma di asta batteri all'interno del biofilm, la perfetta illustrazione. Un biofilm è una colonia di batteri che si forma un rivestimento su una superficie. Luoghi comuni per biofilm da sviluppare sono in bocca, dove possono causare delle cavità del dente e malattie gengivali, su lenti a contatto, dove possono causare infezioni di occhio, sulle rocce sommerso in acqua e sulle attrezzature industriali, dove essi possono provocare incrostazioni.

RFD9NW73–Vista microscopico di Chlamydia. La Chlamydia è una comune malattia sessualmente trasmessa (STD) causata da un batterio.

RM2AHEDM2–Nancy Teo Quintana un primo grado studente dalla sig.ra Lindsay Gormus della classe in Maryland Città scuola elementare di alloro, Maryland guarda attraverso un microscopio per visualizzare la listeria e la salmonella, due dei quattro più comuni batteri presenti nei prodotti alimentari. Gli altri due sono i batteri campylobacter ed e. coli. Il Reparto di Stati Uniti dell'Agricoltura, sicurezza alimentare servizio di ispezione ha tenuto una educazione alla sicurezza alimentare il camp in Maryland Città scuola elementare, gio, 5 maggio 2011.

RM2XPCFT9–Lago salato rosa, Las Salinas de Torrevieja è un lago di colore rosso o rosa. Ciò è spesso causato dalla presenza di alghe tolleranti al sale che producono carotenoidi, come Dunaliella salina, di solito in combinazione con batteri specifici e archea, che possono variare da lago a lago. L'archaeone più comune è l'Halobacterium salinarum.

RMFJ5HFD–Di forsitia comune (coltivazione x intermedia, Forsitia intermedia), con fiele di batteri, Rhodococcus fascians, Germania, Meclemburgo-Pomerania Occidentale
RM2BE0G7W–Numerosi ceppi di batteri Staphylococcus aureus resistenti alla meticillina, comunemente indicati con l'acronimo MRSA. Focolai o cluster recentemente riconosciuti di MRSA in ambienti comunitari sono stati associati a ceppi che hanno alcune proprietà microbiologiche e genetiche uniche rispetto ai ceppi MRSA tradizionali basati in ospedale. Ciò suggerisce che alcune proprietà biologiche, per esempio, fattori di virulenza come le tossine, possono permettere che i ceppi della comunità si diffondano più facilmente o causino più malattia della pelle. Un ceppo comune denominato USA300-0114 ha causato molti focolai di questo tipo negli Stati Uniti. Staphylococcc

RM2NGXWBY–STATI UNITI Air Force Airman 1st Class Tyler Benner, a sinistra, 86th Vehicle Readiness Squadron vehicle operator e Airman 1st Class Jeremy Evans, a destra, 86th VRS Ground Transportation operator, fissare un contenitore di spedizione presso la base aerea di Ramstein, Germania, 30 novembre 2022. Benner dice che non prende più nulla per scontato, dopo essere sopravvissuto a una rara condizione medica che lo ha lasciato in ospedale per mesi. Aggregatibacter aphrophilus, un comune batterio residente in bocca, ha causato il suo sangue a diventare settico e ha portato alla crescita di un ascesso di baseball-dimensione nel suo fegato.

RF2GARB4F–La cometa o il pesce d'oro comune sono morti a causa della scarsa qualità dell'acqua, ad esempio l'avvelenamento da ammoniaca. Pesci morti galleggianti sulla superficie dell'acqua.

RFPXD3AC–Virus influenzale nozione di malattia comune in inverno, medicinali e rimedi contro questa malattia abituale

RF2BRCFXT–Scienza Foto di batteri Candida albicans è un lievito patogeno opportunistico che è un membro comune della flora intestinale umana

RMP8P323–Closeup saltmarsh nel Oosterschelde National Park in ottobre con i colori autunnali e metalic biofilm con ironbacteria indicando ricchi di ferro acqua

RFF0FBJ3–Candida albicans è un fungo diploide che cresce sia come lievito e cellule filamentose e un agente causale di opportunisti e orale

RME8KPGE–Batteri di Salmonella, una causa comune di avvelenamento di cibo, di invadere una cellula immune.

RFHNAGRA–Batteri di forma sferica e a forma di asta batteri all'interno di un biofilm, illustrazione. Un biofilm è una colonia di batteri che si forma un rivestimento su una superficie. Luoghi comuni per biofilm da sviluppare sono in bocca, dove possono causare delle cavità del dente e malattie gengivali, su lenti a contatto, dove possono causare infezioni di occhio, sulle rocce sommerso in acqua e sulle attrezzature industriali, dove essi possono provocare incrostazioni.

RFDCG388–Vista microscopico di Chlamydia. La Chlamydia è una comune malattia sessualmente trasmessa (STD) causata da un batterio.

RM2AHEDK8–Dott.ssa Elisabetta Hagen (sinistra), il Sottosegretario alla sicurezza alimentare e Emily Wise (a destra), uno studente di quinta in Maryland Città scuola elementare di alloro, Maryland guardare attraverso i microscopi per visualizzare la listeria e la salmonella, due dei quattro più comuni batteri presenti nei prodotti alimentari. Gli altri due sono i batteri campylobacter ed e. coli. Alle spalle di Hagen e saggi sono il dottor Kevin Concannon, Sottosegretario di consumo alimentare e nutrizione servizi e Barbara Robinson, Sicurezza Alimentare Servizio di ispezione. Il FSIS ha tenuto una educazione alla sicurezza alimentare il camp in Maryland Città scuola elementare, Giovedi, 5 maggio 2011

RF2DH78BR–Batteri comuni che infettano l'uomo. I batteri di illustrazione di vettore sono classificati in 5 gruppi secondo la loro forma di base: Sferico (cocchi)

RM2XPCF6R–Lago salato rosa, Las Salinas de Torrevieja è un lago di colore rosso o rosa. Ciò è spesso causato dalla presenza di alghe tolleranti al sale che producono carotenoidi, come Dunaliella salina, di solito in combinazione con batteri specifici e archea, che possono variare da lago a lago. L'archaeone più comune è l'Halobacterium salinarum.

RF2ATPX05–Foglio di carta strappato con l'iscrizione Coronavirus 2019-nCoV. Il concetto di vittoria comune su un virus pericoloso

RM2YKN40W–Foto del file datata 19/05/08 di una donna che guarda la materia sotto un microscopio. I batteri della Salmonella potrebbero essere usati per curare il cancro intestinale, gli scienziati sperano. Il cancro intestinale è la seconda causa più comune di morte per cancro nel Regno Unito dopo il cancro ai polmoni, con circa 16.800 morti all'anno. Secondo Cancer Research UK, la Scozia è colpita in modo "sproporzionato", con circa 4.000 persone che vengono diagnosticate ogni anno. Data di pubblicazione: Martedì 19 novembre 2024.
RM2BE0G9W–Numerosi ceppi di batteri Staphylococcus aureus resistenti alla meticillina, comunemente indicati con l'acronimo MRSA. Focolai o cluster recentemente riconosciuti di MRSA in ambienti comunitari sono stati associati a ceppi che hanno alcune proprietà microbiologiche e genetiche uniche rispetto ai ceppi MRSA tradizionali basati in ospedale. Ciò suggerisce che alcune proprietà biologiche, per esempio, fattori di virulenza come le tossine, possono permettere che i ceppi della comunità si diffondano più facilmente o causino più malattia della pelle. Un ceppo comune denominato USA300-0114 ha causato molti focolai di questo tipo negli Stati Uniti. Staphylococcc

RM2NGXWCT–STATI UNITI Air Force Airman 1st Class Tyler Benner, destra, 86th Vehicle Readiness Squadron Vehicle Operator e Airman 1st Class Jeremy Evans, sinistra, 86th VRS Ground Transport Operator, fissare un contenitore di spedizione presso la base aerea di Ramstein, Germania, 30 novembre 2022. Benner ha fatto mettere in pausa la sua vita quando costretto a trascorrere mesi in ospedale a causa di una rara condizione medica che ha causato la crescita di un ascesso sul suo fegato. Aggregatibacter aphrophilus, un comune batterio residente in bocca, ha causato il suo sangue a diventare settico e ha portato alla crescita di un ascesso di baseball-dimensione nel suo fegato.

RF3D38YBB–frutto di mango marcire a causa di una malattia fungina, probabilmente antracnosi o muffa in polvere, antracnosio è una malattia fungina comune che colpisce il mango e la fru

RMK42BC7–Rotifer Collotheca, alimentando sui batteri con extended cilla, una ganascia-come dispositivo per la macinazione di particelle di cibo, comune bdelloid rotifer trovata nel Bagno uccelli

RF2HH9APA–Radice di soia infettata da una malattia che provoca l'intera pianta a scriciolarsi e produrre perdite.

RF2B62NW8–Lavaggio efficace delle mani con sapone per ridurre il rischio di infezioni comuni. Femmina sul lavandino del bagno con acqua corrente che sfrega le mani con sapone bianco bar

RME8KPGG–Batteri di Salmonella, una causa comune di avvelenamento di cibo, di invadere una cellula immune.

RFHNAGRD–Batteri di forma sferica e a forma di asta batteri all'interno di un biofilm, illustrazione. Un biofilm è una colonia di batteri che si forma un rivestimento su una superficie. Luoghi comuni per biofilm da sviluppare sono in bocca, dove possono causare delle cavità del dente e malattie gengivali, su lenti a contatto, dove possono causare infezioni di occhio, sulle rocce sommerso in acqua e sulle attrezzature industriali, dove essi possono provocare incrostazioni.

RM2C6MY7N–Dott.ssa Elisabetta Hagen (sinistra), il Sottosegretario alla sicurezza alimentare e Emily Wise (a destra), uno studente di quinta in Maryland Città scuola elementare di alloro, Maryland guardare attraverso i microscopi per visualizzare la listeria e la salmonella, due dei quattro più comuni batteri presenti nei prodotti alimentari. Gli altri due sono i batteri campylobacter ed e. coli. Alle spalle di Hagen e saggi sono il dottor Kevin Concannon, Sottosegretario di consumo alimentare e nutrizione servizi e Barbara Robinson, Sicurezza Alimentare Servizio di ispezione. Il FSIS ha tenuto una educazione alla sicurezza alimentare il camp in Maryland Città scuola elementare, Giovedi, 5 maggio 2011

RF2DH78BT–Batteri comuni infettando umano. Illustrazione vettoriale. I batteri sono classificati in 5 gruppi in base alle loro forme di base: Sferiche (cocci), verga

RM2XPCF6T–Lago salato rosa, Las Salinas de Torrevieja è un lago di colore rosso o rosa. Ciò è spesso causato dalla presenza di alghe tolleranti al sale che producono carotenoidi, come Dunaliella salina, di solito in combinazione con batteri specifici e archea, che possono variare da lago a lago. L'archaeone più comune è l'Halobacterium salinarum.

RM3A3TFA0–EMBARGO AL 0001 MARTEDÌ 19 NOVEMBRE foto del file datata 19/05/08 di una donna che guarda la materia sotto un microscopio. I batteri della Salmonella potrebbero essere usati per curare il cancro intestinale, gli scienziati sperano. Il cancro intestinale è la seconda causa più comune di morte per cancro nel Regno Unito dopo il cancro ai polmoni, con circa 16.800 morti all'anno. Secondo Cancer Research UK, la Scozia è colpita in modo "sproporzionato", con circa 4.000 persone che vengono diagnosticate ogni anno. Data di pubblicazione: Martedì 19 novembre 2024.
RM2BE0G7M–Numerosi ceppi di batteri Staphylococcus aureus resistenti alla meticillina, comunemente indicati con l'acronimo MRSA. Focolai o cluster recentemente riconosciuti di MRSA in ambienti comunitari sono stati associati a ceppi che hanno alcune proprietà microbiologiche e genetiche uniche rispetto ai ceppi MRSA tradizionali basati in ospedale. Ciò suggerisce che alcune proprietà biologiche, per esempio, fattori di virulenza come le tossine, possono permettere che i ceppi della comunità si diffondano più facilmente o causino più malattia della pelle. Un ceppo comune denominato USA300-0114 ha causato molti focolai di questo tipo negli Stati Uniti. Staphylococcc

RF3D38YCT–Mucchio di frutta di mango marcire a causa di una malattia fungina, probabilmente antracnosi o muffa in polvere, antracnosio è una malattia fungina comune che colpisce il mango

RFFJX605–Malattia umana la diffusione di agenti patogeni microscopici sono in corso di diffusione attraverso una bocca aperta che è la tosse o gli starnuti trasmettere la malattia e contagioso virus o batteri come pericolosi airborne germi.

RF2ERN5GC–Crisi sanitaria globale in Covid-19 e concetto di vaccino: 3d rese cellule di coronavirus con bandiera spagnola fluttuante in background sangue

RME8KPGF–Batteri di Salmonella, una causa comune di avvelenamento di cibo, di invadere una cellula immune.

RFMYDRC3–Computer illustrazione di Bacteroides sp. batteri. Questi sono a forma di asta, obbligherà anaerobico gram-negativi, saccharolytic batteri. Il Bacteroides sono i più comuni batteri trovati nell'umana intestinale. Essi sono coinvolti in molte importanti attività metaboliche nella flora umano del colon, compresa la fermentazione di carboidrati, l'utilizzazione di sostanze azotate, e la biotrasformazione di acidi biliari e altri steroidi. Quando il Bacteroides sfuggire il colon, essi sono responsabili di molti tipi di infezioni e ascessi che possono verificarsi in tutto il corpo compresa la parte superiore del corpo,

RM2J1J20K–Lichen arancione comune, scala gialla, Xantoria parietina, su ramo rotto senza corteccia. Abruzzo, Italia, Europa

RF2Y2D1Y8–Miocardite. Sezione trasversale di un cuore umano e le cause più comuni di malattia come Protozoa, batteri, parassiti, funghi, virus. Illustrazione vettoriale

RM2XPCFMT–Lago salato rosa, Las Salinas de Torrevieja è un lago di colore rosso o rosa. Ciò è spesso causato dalla presenza di alghe tolleranti al sale che producono carotenoidi, come Dunaliella salina, di solito in combinazione con batteri specifici e archea, che possono variare da lago a lago. L'archaeone più comune è l'Halobacterium salinarum.

RM2ATWH34–Foro batterico (Pseudomonas syringae) ha colpito foglie di alloro, Prunus laurocerasus, in una siepe giardino, Berkshire, Inghilterra, Regno Unito. Maggio.

RF3D394N2–Mucchio di frutta di mango marcire a causa di una malattia fungina, probabilmente antracnosi o muffa in polvere, antracnosio è una malattia fungina comune che colpisce il mango

RFDCG380–Vista microscopico di Chlamydia. La Chlamydia è una comune malattia sessualmente trasmessa (STD) causata da un batterio.

RF2ERN5AG–Crisi sanitaria globale in Covid-19 e concetto di vaccino: 3d rese cellule di coronavirus con bandiera russa fluttuante in background sangue. Nazionale

RM2JKFTMJ–I batteri della salmonella, una causa comune di avvelenamento da cibo, hanno invaso una cellula immune.

RFMYDRC5–Computer illustrazione di Bacteroides sp. batteri. Questi sono a forma di asta, obbligherà anaerobico gram-negativi, saccharolytic batteri. Il Bacteroides sono i più comuni batteri trovati nell'umana intestinale. Essi sono coinvolti in molte importanti attività metaboliche nella flora umano del colon, compresa la fermentazione di carboidrati, l'utilizzazione di sostanze azotate, e la biotrasformazione di acidi biliari e altri steroidi. Quando il Bacteroides sfuggire il colon, essi sono responsabili di molti tipi di infezioni e ascessi che possono verificarsi in tutto il corpo compresa la parte superiore del corpo,